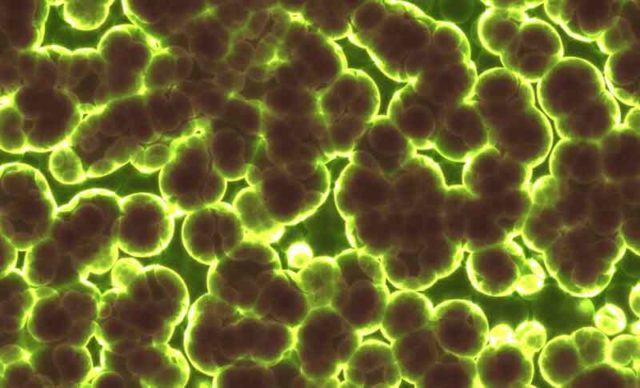

Kesehatan
Para ilmuwan telah menciptakan embrio buatan dan memulai kehamilan pada tikus
Agar janin berkembang menjadi bayi yang sehat, tahap awal kehamilan sangat penting. Jika ada yang salah, kehamilan mungkin tidak akan terjadi, atau bayi mungkin mengalami masalah kesehatan di kemudian hari. Masalahnya, saat ini, dokter tidak tahu cara mengintervensi jika masalah seperti itu muncul. Mereka tidak bisa melihat apa yang terjadi dengan embrio sesaat setelah pembuahan, apalagi mengembangkan perawatan untuk mengatasi masalah. Tapi itu...
Debu Bulan Bisa Merusak Sel dan DNA
Astronot yang berharap dapat tinggal di bulan untuk misi jangka panjang memiliki alasan lain untuk merasakan kekhawatiran dikarenakan debu bulan: Ini bisa sangat berbahaya jika terhirup, seperti yang ditunjukkan oleh penelitian terbaru. Kita sudah lama tahu bahwa debu bulan bisa menimbulkan masalah. Selama misi Apollo, astronot mengeluhkan bersin dan mata berair setelah terpapar debu dari pakaian antariksa mereka saat kembali ke...
Mana yang lebih baik, satu atau dua spasi setelah satu periode dalam satu kalimat?
Sekelompok peneliti di Skidmore College menemukan bahwa teks dengan dua spasi setelah periode dalam kalimat memungkinkan orang memproses informasi yang mereka baca lebih cepat. Dalam makalahnya yang diterbitkan di jurnal Attention, Persception, dan Psychophysics , Rebecca Johnson, Becky Bui dan Lindsay Schmitt menguraikan studi mereka dan apa yang mereka temukan. Orang yang cukup tua untuk menggunakan mesin tik biasanya diajarkan untuk memasukkan dua...
Terungkap Penyakit Mematikan Sultan Saladin
Sultan Saladin mungkin kurang dikenal di Barat, tetapi hingga 800 tahun setelah kematiannya, ia bahkan tetap terkenal di Timur Tengah dan dalam sejarah peradaban Islam. Ia dilahirkan pada tahun 1137, dan bangkit menjadi seorang Sultan di daerah yang sangat besar yang sekarang mencakup Mesir, Suriah, sebagian Irak, Libanon, Yaman, dan daerah lain di Afrika Utara. Dia berhasil memimpin pasukannya melawan...
Tanpa Hewan Peliharaan, Meningkatkan Kerentanan Terhadap Penyakit Mental
Anak-anak yang dibesarkan di lingkungan pedesaan, dikelilingi oleh hewan dan debu yang dipenuhi bakteri, tumbuh menjadi lebih tahan terhadap tekanan sistem kekebalan tubuh dan mungkin memiliki risiko penyakit mental yang lebih rendah daripada penduduk kota bebas hewan peliharaan, menurut penelitian baru yang diterbitkan minggu ini di yang Prosiding National Academy of Sciences (PNAS). Studi ini, yang ditulis bersama oleh para peneliti...
Musik Mengaktifkan Daerah otak yang terhindar dari penyakit Alzheimer
Pernah merinding saat mendengarkan musik yang sangat menyentuh? Anda dapat berterima kasih kepada jaringan kecerdasan otak untuk lipatan emosional ini. Anehnya, wilayah ini juga tetap menjadi pulau ingatan yang terhindar dari kerusakan akibat penyakit Alzheimer. Para peneliti di University of Utah Health mencari wilayah di otak ini untuk mengembangkan perawatan berbasis musik untuk membantu meringankan kecemasan pada pasien dengan demensia. Penelitian mereka akan...
Ingin Mengingat Mimpi? Coba Vitamin B6
Penelitian baru dari University of Adelaide menemukan bahwa mengonsumsi vitamin B6 dapat membantu orang untuk mengingat mimpi mereka. Studi yang diterbitkan online dengan judul Perceptual and Motor Skills, melibatkan 100 peserta dari seluruh Australia yang mengonsumsi suplemen vitamin B6 dosis tinggi sebelum tidur selama lima hari berturut-turut. "Hasil kami menunjukkan bahwa mengonsumsi vitamin B6 meningkatkan kemampuan orang untuk mengingat mimpi dibandingkan...
Bakteri Berkomunikasi Untuk Menghindari Antibiotik, Ungkap Studi
Dalam sebuah studi baru yang diterbitkan dalam Journal of Biological Chemistry ( JBC ), para peneliti dari University of Notre Dame dan University of Illinois Urbana-Champaign telah menemukan bahwa bakteri Pseudomonas aeruginosa, patogen yang menyebabkan pneumonia, sepsis dan infeksi lainnya, mengkomunikasikan sinyal marabahaya dalam sekelompok bakteri sebagai respons terhadap antibiotik tertentu. Komunikasi ini ditemukan bervariasi di seluruh koloni dan menunjukkan bahwa bakteri ini dapat mengembangkan...
Cokelat Hitam Mungkin Dapat Memperbaiki Penglihatan
Memang ini tidak akan menggantikan resep kacamata, tetapi beberapa gigitan cokelat hitam dapat menawarkan sedikit dan sementara peningkatan kualitas dalam penglihatan, demikian temuan penelitian baru. Senyawa sehat dalam coklat yang disebut flavanols muncul untuk mempertajam penglihatan untuk sekelompok 30 orang dewasa muda yang sehat dalam studi baru. Perubahan penglihatan yang diamati kecil, tetapi signifikan. Namun, penulis penelitian menekankan bahwa terlalu dini...
Aktivitas Fisik yang Kuat Terkait dengan Peningkatan Risiko ALS, Dan Tidak Ada Yang Tahu Mengapa
Melakukan latihan fisik secara teratur adalah salah satu hal terbaik yang dapat Anda lakukan untuk tubuh Anda, tetapi itu juga dapat menyebabkan risiko tinggi mengembangkan amyotrophic lateral sclerosis (ALS), menurut penelitian baru. ALS - alias penyakit neuron motorik atau penyakit Lou Gehrig - paling dikenal saat ini sebagai kondisi neurodegeneratif yang memengaruhi Stephen Hawking, tetapi masih banyak yang tidak kita...